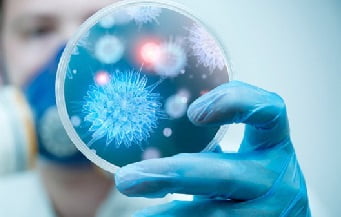
Полиомиелит причины

Полиомиелит — это острое вирусное заболевание, поражающее центральную нервную систему, в первую очередь спинной мозг, и иногда вызывающее паралич. Основным способом распространения считается прямой или непрямой контакт с больным (через руки, носовые платки, одежду и т.п.). Также распространяется через продукты, воду, с воздухом.
Полиомиелит — это острое вирусное заболевание, поражающее центральную нервную систему, в первую очередь спинной мозг, и иногда вызывающее паралич. Основным способом распространения считается прямой или непрямой контакт с больным (через руки, носовые платки, одежду и т.п.). Также распространяется через продукты, воду, с воздухом.
Что это такое? Возбудителем полиомиелита являются полиовирусы (poliovirus hominis) семейства Picornaviridae рода Enterovirus. Выделяют три серотипа вируса (преобладает I тип): I — Брунгильда (выделен от больной обезьяны с той же кличкой), II -Лансинг (выделен в местечке Лансинг) и III -Леон (выделен от больного мальчика Маклеона).
В некоторых случаях заболевание протекает в стертой или бессимптомной форме. Человек может являться носителем вируса, выделяя его во внешнюю среду вместе с калом и выделениями из носа, и при этом чувствовать себя абсолютно здоровым. Между тем восприимчивость к полиомиелиту достаточно высокая, что чревато быстрым распространением заболевания среди детского населения.
Как передается полиомиелит, и что это такое?
Полиомиели́т (от др.-греч. πολιός — серый и µυελός — спинной мозг) — детский спинномозговой паралич, острое, высококонтагиозное инфекционное заболевание, обусловленное поражением серого вещества спинного мозга полиовирусом и характеризующееся преимущественно патологией нервной системы.
В основном протекает в бессимптомной или стертой форме. Иногда случается так, что полиовирус проникает в ЦНС, размножается в мотонейронах, что приводит к их гибели, необратимым парезам или параличам иннервируемых ими мышц.
Заражение происходит несколькими путями:
- Воздушно-капельный путь — реализуется при вдыхании воздуха с взвешенными в нем вирусами.
- Алиментарный путь передачи — заражение происходит при употреблении в пищу загрязненных продуктов питания.
- Контактно-бытовой путь — возможен при использовании одной посуды для приема пищи разными людьми.
- Водный путь — вирус попадает в организм с водой.
Особенно опасными в инфекционном плане являются лица, переносящие заболевания бессимптомно (в инаппаратной форме) или с неспецифическими проявлениями (небольшой лихорадкой, общей слабостью, повышенной утомляемостью, головной болью, тошнотой, рвотой) без признаков поражения ЦНС. Такие люди могут заразить большое количество контактирующих с ними, т.к. диагноз заболевшим поставить очень сложно, а, следовательно, изоляции эти лица практически не подвергаются.
Прививка от полиомиелита
Специфическая профилактика — это вакцинация против полиомиелита. Существует 2 типа вакцин против полиомиелита:
- живая вакцина Себина (ОПВ — содержит живые ослабленные вирусы)
- инактивированная (ИПВ — содержит полиовирусы всех трех серотипов, убитых формалином).
В настоящее время единственный производитель вакцины против полиомиелита на территории России ФГУП «Предприятие по производству бактерийных и вирусных препаратов Института полиомиелита и вирусных энцефалитов им. М.П. Чумакова» выпускает только живые вакцины против полиомиелита.
Другие препараты для проведения вакцинации традиционно закупаются за рубежом. Однако в феврале 2015 года предприятие представило первые образцы инактивированной вакцины собственной разработки. Начало её использования запланировано на 2017 год.

Симптомы полиомиелита
Согласно данным ВОЗ полиомиелит поражает, в основном, детей в возрасте до 5 лет. Инкубационный период длится от 5 до 35 дней, симптомы зависят от формы полиомиелита. По статистике чаще всего заболевание протекает без нарушения двигательных функций — на один паралитический случай приходится десять непаралитических. Начальной формой заболевания выступает форма препаралитическая (непаралитический полиомиелит). Для нее характерны следующие симптомы:
- Недомогание общего характера;
- Повышение температуры в пределах до 40°C;
- Снижение аппетита;
- Тошнота;
- Рвота;
- Мышечные боли;
- Боли в горле;
- Головные боли.
Перечисленные симптомы в течение одной-двух недель постепенно исчезают, однако в некоторых случаях могут длиться и более долгий срок. В результате головной боли и лихорадки возникают симптомы, свидетельствующие о поражении нервной системы.
В этом случае больной становится более раздражительным и беспокойным, наблюдается эмоциональная лабильность (неустойчивость настроения, постоянное его изменение). Также возникает ригидность мышц (то есть их онемелость) в области спины и шеи, проявляются указывающие на активное развитие менингита признаки Кернига-Брудзинского. В дальнейшем перечисленные симптомы препаралитической формы могут перерасти в форму паралитическую.
Абортивная форма полиомиелита
При абортивной форме полиомиелита больные дети жалуются на повышение температуры тела до 38 °С. На фоне температуры наблюдают:
- недомогание;
- слабость;
- вялость;
- несильную головную боль;
- кашель;
- насморк;
- боль в животе;
- рвоту.
Кроме того, наблюдается покраснение горла, энтероколит, гастроэнтерит или катаральная ангина как сопутствующие диагнозы. Длительность срока проявления данных симптомов составляет порядка 3-7 дней. Полиомиелит в данной форме характеризуется ярко выраженным кишечным токсикозом, в целом имеется значительное сходство в проявлениях с дизентерией, течение заболевания также может быть холероподобным.
Менингиальная форма полиомиелита
Данная форма характеризуется собственной остротой, при этом отмечаются аналогичные с предыдущей формой симптомы:
- температура;
- общая слабость;
- недомогание;
- боли в животе;
- головные боли различной степени интенсивности;
- насморк и кашель;
- снижение аппетита;
- рвота.
При осмотре горло красное, может быть налет на нёбных дужках и миндалинах. Такое состояние длится 2 дня. Затем температура тела нормализуется, уменьшаются катаральные явления, ребенок выглядит здоровым в течение 2-3 дней. После этого начинается второй период повышения температуры тела. Жалобы становятся более отчетливыми:
- резкое ухудшение состояния;
- сильная головная боль;
- рвота;
- боль в спине и конечностях, как правило, ногах.
При объективном обследовании диагностируют симптомы, характерные для менингизма (положительность симптома Кернига и Брудзинского, ригидность в области спины и затылочных мышц). Улучшение состояния достигается ко второй неделе.
Паралитический полиомиелит
Развивается достаточно редко, но, как правило, приводит к нарушению многих функций организма и, соответственно, к инвалидности:
- Бульбарная. Особую тяжесть составляет развитие бульбарного паралича. Поражается вся группа каудальных нервов. Избирательное поражение одного, двух нервов для полиомиелита нетипично. При поражении ретикулярной формации, дыхательного и сосудистого центров может нарушаться сознание, дыхательные расстройства центрального генеза.
- Понтинная. Для этого вида полиомиелита характерно развитие парезов и параличей лицевого нерва, при которых происходит частичная или полная утрата мимических движений.
- Энцефалитическая. Поражается вещество мозга и подкорковые ядра (очень редко). Развиваются центральные парезы, судорожный синдром, афазия, гиперкинезы.
- Спинальная. Слабость и боль в мышцах постепенно сменяются параличом, как общим, так и частичным. Поражение мышц при данной форме полиомиелита может быть симметричным, но встречается паралич отдельных групп мышц по всему туловищу.
В течении заболевания выделяют 4 периода:
- препаралитический;
- паралитический;
- восстановительный;
- резидуальный.
Препаралитическая стадия
Отличается довольно острым началом начало, высокими цифрами температуры тела, общим недомоганием, головной болью, расстройствами ЖКТ, ринитом, фарингитом. Такая клиническая картина сохраняется 3 дня, далее состояние нормализируется на 2-4 суток. После наступает резкое ухудшение состояния с теми же симптомами, но более выраженной интенсивности. Присоединяются такие признаки:
- боль в ногах, руках, спине;
- снижение рефлексов;
- повышенная чувствительность;
- понижение силы мышц;
- судороги;
- спутанность сознания;
- чрезмерная потливость;
- пятна на коже;
- «гусиная кожа».
Паралитическая стадия
Это стадия, когда внезапно больного разбивает паралич (за пару часов). Длиться эта стадия от 2-3 до 10-14 дней. Больные на этот период часто погибают от тяжелого расстройства дыхания и кровообращения. Он имеет такие симптомы:
- вялый паралич;
- расстройства акта дефекации;
- пониженный тонус мышц;
- ограничение или полное отсутствие активных движений в конечностях, теле;
- поражение преимущественно мышц рук и ног, но могут пострадать и мышцы шеи, туловища;
- спонтанный болевой мышечный синдром;
- повреждение продолговатого мозга;
- расстройства мочеиспускания;
- поражение и паралич диафрагмы и дыхательных мышц.
В восстановительном периоде полиомиелита, который длится до 1 года, происходит постепенная активизация сухожильных рефлексов, восстанавливаются движения в отдельных мышечных группах. Мозаичность поражения и неравномерность восстановления обусловливает развитие атрофии и мышечных контрактур, отставание пораженной конечности в росте, формирование остеопороза и атрофии костной ткани.
Резидуальный период, или период остаточных явлений, характеризуется наличием стойких парезов и параличей, сопровождающихся мышечной атрофией и трофическими расстройствами, развитием контрактур и деформацией в пораженных конечностях и участках тела.
Постполиомиелитный синдром
После перенесенного полиомиелита у некоторых пациентов на долгие годы (в среднем 35 лет) сохраняются ограниченные возможности и ряд проявлений, наиболее частые из которых:
- прогрессирующая мышечная слабость и боль;
- общая разбитость и усталость после минимальных нагрузок;
- атрофия мышц;
- нарушения дыхания и глотания;
- нарушения дыхания во сне, особенно ночное апноэ;
- плохая переносимость низких температур;
- когнитивные нарушения — такие, как снижение концентрации внимания и трудности с запоминанием;
- депрессия или перепады настроения.
Диагностика
В случае полиомиелита диагностика основывается на лабораторных исследованиях. В первую неделю заболевания вирус полиомиелита может быть выделен из секрета носоглотки, а начиная со второй — из каловых масс. В отличие от других энтеровирусов, возбудителя полиомиелита крайне редко удается изолировать из спинномозговой жидкости.
При невозможности изоляции и изучения вируса проводится серологический анализ, в основе которого лежит выделение специфических антител. Данный метод является довольно чувствительным, однако он не позволяет различать постпрививочную и естественную инфекции.
Лечение
Мероприятия, направленные против полиомиелита, требуют обязательной госпитализации. Назначаются постельный режим, прием обезболивающих и успокоительных, а также тепловые процедуры.
При параличах проводится комплексное восстановительное лечение, а затем поддерживающее лечение в санаторно-курортных зонах. Такие осложнения полиомиелита как нарушения дыхания требуют срочных мер по восстановлению дыхания и реанимации пациента. Очаг заболевания подлежит дезинфекции.
Прогноз для жизни
Легкие формы полиомиелита (протекающие без поражения ЦНС и менингеальная) проходят бесследно. Тяжелые паралитические формы могут приводить к стойкой инвалидизации и летальному исходу.
Благодаря многолетней целенаправленной вакцинопрофилактике полиомиелита в структуре заболевания преобладают легкие инаппарантная и абортивная формы инфекции; паралитические формы возникают только у невакцинированных лиц.

Профилактика
Неспецифическая направлена на общее укрепление организма, увеличение его устойчивости к различным инфекционным агентам (закаливание, правильное питание, своевременная санация хронических очагов инфекции, регулярные физические нагрузки, оптимизация цикла сон-бодровствание и др.), борьба с насекомыми, которые являются разносчиками патогенных микроорганизмов (различные виды дезинсекции), соблюдение правил личной гигиены (в первую очередь это мытье рук после улицы и после посещения туалета), тщательная обработка овощей, фруктов и других продуктов перед употреблением их в пищу.
Для предотвращения развития полиомиелита используется вакцинация, которая проводится с помощью живых ослабленных вирусов — они не могут вызвать развитие заболевания, но вызывают специфический иммунный ответ организма с формированием длительного устойчивого иммунитета. С этой целью в большинстве стран мира противополиомиелитная вакцинация включена в календарь обязательных прививок. Современные вакцины являются поливалентными — содержат все 3 серологические группы вируса полиомиелита.
Полиомиелит сегодня — это очень редкая инфекция благодаря применению вакцинации. Несмотря на это, отдельные случаи заболевания еще регистрируются на планете. Поэтому знание основных симптомов и способов профилактики просто необходимо. Предупрежден — значит вооружен!
Глобальное число случаев заболевания
С 1988 года число случаев заболевания полиомиелитом уменьшилось более чем на 99%. По оценкам, с 350 000 случаев более чем в 125 эндемичных странах до 359 случаев, зарегистрированных в 2014 году. Сегодня эндемичными по этой болезни остаются лишь отдельные территории двух стран мира с минимальной за всю историю площадью.
Из 3 штаммов дикого полиовируса (тип 1, тип 2 и тип 3) дикий полиовирус 2-го типа был ликвидирован в 1999 году, а число заболевших от дикого полиовируса третьего типа сократилось до самого низкого в истории уровня — с ноября 2012 года в Нигерии не было зарегистрировано новых случаев заболевания.
